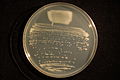
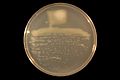
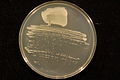
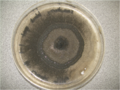
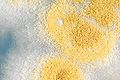
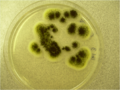
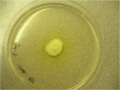
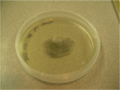
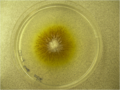
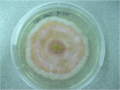
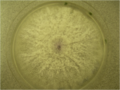
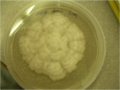
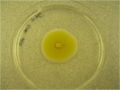
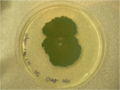
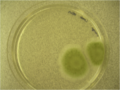
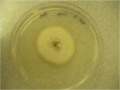
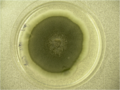
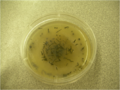
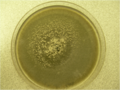

-
The basic structure of nod factors
-
NodARc-IV (Me,Cb,16:0) from Azorhizobium caulinodans
-
NodARc-IV (Me,Cb,16:0,Fuc) from Azorhizobium caulinodans
-
NodARc-IV (Me,Cb,C18:0) from Azorhizobium caulinodans
-
NodARc-IV (Me,Cb,C18:0,Fuc) from Azorhizobium caulinodans
-
NodARc-IV (Me,Cb,C18:0,Fuc,Ara) from Azorhizobium caulinodans
-
NodARc-IV (Me,Cb,C18:1) from Azorhizobium caulinodans
-
NodARc-IV (Me,Cb,C18:1,Fuc) from Azorhizobium caulinodans
-
NodARc-IV (Me,Cb,C18:1,Fuc,Ara) from Azorhizobium caulinodans
-
NodARc-V (Me,C16:0) from Azorhizobium caulinodans
-
NodARc-V (Me,Cb,C16:0 from Azorhizobium caulinodans
-
NodARc-V (Me,C18:0) from Azorhizobium caulinodans
-
NodARc-V (Me,Cb,C18:0 from Azorhizobium caulinodans
-
NodARc-V (Me,Cb,C18-0,(C3)Ara) from Azorhizobium caulinodans
-
NodARc-V (Me,Cb,C18-0,(C6)Ara) from Azorhizobium caulinodans
-
NodARc-V (Me,Cb,C18-0,Fuc) from Azorhizobium caulinodans
-
NodARc-V (Me,Cb,C18-0,Fuc,Ara) from Azorhizobium caulinodans
-
NodARc-V (Me,C18:1) from Azorhizobium caulinodans
-
NodARc-V (Me,Cb,C18:1 from Azorhizobium caulinodans
-
NodARc-V (Me,Cb,C18:1,(C3)Ara) from Azorhizobium caulinodans
-
NodARc-V (Me,Cb,C18:1,(C6)Ara) from Azorhizobium caulinodans
-
NodARc-V (Me,Cb,C18:1,Fuc) from Azorhizobium caulinodans
-
NodARc-V (Me,Cb,C18:1,Fuc,Ara) from Azorhizobium caulinodans
-
NodBj-IV (C18:1,MeFuc) from Bradyrhizobium japonicum
-
NodBj-IV (Cb,C18:1,MeFuc) from Bradyrhizobium japonicum
-
NodBj-IV (C18:1,Fuc,Gro) from Bradyrhizobium japonicum
-
NodBj-IV (Me,C18:1,Fuc,Gro) from Bradyrhizobium japonicum
-
NodBj-IV (Cb,C18:1,Fuc,Gro) from Bradyrhizobium japonicum
-
NodBj-IV (Me,Cb,C18:1,Fuc,Gro) from Bradyrhizobium japonicum
-
NodBj-V (C16:0,MeFuc) from Bradyrhizobium japonicum
-
NodBj-V (Ac,C16:0,MeFuc) from Bradyrhizobium japonicum
-
NodBj-V (C16:1,MeFuc) from Bradyrhizobium japonicum
-
NodBj-V (C18:1,MeFuc) from Bradyrhizobium japonicum
-
NodBj-V (Ac,C18:1,MeFuc) from Bradyrhizobium japonicum
-
NodBj-V (Cb,Ac,C18:1,MeFuc) from Bradyrhizobium japonicum
-
NodBj-V (Me,Cb,C18:1,MeFuc) from Bradyrhizobium japonicum
-
NodMl-V (Me,C18:1,Fuc) from Mesorhizobium loti
-
NodMl-V (Me,Cb,C18:1,Fuc) from Mesorhizobium loti
-
NodMl-V (Me,Cb,C18:1,AcFuc) from Mesorhizobium loti
-
NodRe-V (Me,18:0,AcFuc) from Rhizobium etli
-
NodRe-V (Me,Cb,18:0,AcFuc) from Rhizobium etli
-
NodRe-V (Me,18:1,AcFuc) from Rhizobium etli
-
NodRe-V (Me,Cb,18:1,AcFuc) from Rhizobium etli
-
NodRlv-IV (Ac,C18:1) from Rhizobium leguminosarum bv. viciae
-
NodRlv-IV (Ac,C18:4) from Rhizobium leguminosarum bv. viciae
-
NodRlv-V (Ac,C18:1) from Rhizobium leguminosarum bv. viciae
-
NodRlv-V (Ac,C18:4) from Rhizobium leguminosarum bv. viciae
-
NodRt-V (Me,18:1) from Rhizobium tropici
-
NodRt-V (Me,18:1,S) from Rhizobium tropici
-
NodSf-III (C18:1,Fuc) from Sinorhizobium fredii
-
NodSf-III (C18:1,MeFuc) from Sinorhizobium fredii
-
NodSf-IV (C18:1,Fuc) from Sinorhizobium fredii
-
NodSf-IV (C18:1,MeFuc) from Sinorhizobium fredii
-
NodSf-V (C18:1,Fuc) from Sinorhizobium fredii
-
NodSf-V (C18:1,MeFuc) from Sinorhizobium fredii
-
NodSm-III (C16:1,S) from Sinorhizobium meliloti
-
NodSm-III (Ac,C16:1,S) from Sinorhizobium meliloti
-
NodSm-III (C16:2,S) from Sinorhizobium meliloti
-
NodSm-III (Ac,C16:2,S) from Sinorhizobium meliloti
-
NodSm-III (C16:3,S) from Sinorhizobium meliloti
-
NodSm-III (Ac,C16:3,S) from Sinorhizobium meliloti
-
NodSm-IV (C16:1,S) from Sinorhizobium meliloti
-
NodSm-IV (Ac,C16:1,S) from Sinorhizobium meliloti
-
NodSm-IV (C16:2,S) from Sinorhizobium meliloti
-
NodSm-IV (Ac,C16:2,S) from Sinorhizobium meliloti
-
NodSm-IV (C16:3,S) from Sinorhizobium meliloti
-
NodSm-IV (Ac,C16:3,S) from Sinorhizobium meliloti
-
NodSm-IV (Ac,C18:0(ω-1),S) from Sinorhizobium meliloti
-
NodSm-IV (Ac,C18:1,S) from Sinorhizobium meliloti
-
NodSm-IV (Ac,C20:0(ω-1),S) from Sinorhizobium meliloti
-
NodSm-IV (Ac,C20:1,S) from Sinorhizobium meliloti
-
NodSm-IV (Ac,C22:0(ω-1),S) from Sinorhizobium meliloti
-
NodSm-IV (Ac,C24:0(ω-1),S) from Sinorhizobium meliloti
-
NodSm-IV (Ac,C26:0(ω-1),S) from Sinorhizobium meliloti
-
NodSm-V (C16:1,S) from Sinorhizobium meliloti
-
NodSm-V (Ac,C16:1,S) from Sinorhizobium meliloti
-
NodSm-V (C16:2,S) from Sinorhizobium meliloti
-
NodSm-V (Ac,C16:2,S) from Sinorhizobium meliloti
-
NodSm-V (C16:3,S) from Sinorhizobium meliloti
-
NodSm-V (Ac,C16:3,S) from Sinorhizobium meliloti
|

.svg/120px-Succinic_Acid_(Lactonized).svg.png)















-beta-(1%2c3)-glucan_of_Bradyrhizobium_japonicum.svg/120px-Cyclic_beta-(1%2c6)-beta-(1%2c3)-glucan_of_Bradyrhizobium_japonicum.svg.png)








.svg/118px-Sinorhizobium_meliloti_galactoglucan_(EPS_II).svg.png)


























.svg/120px-NodARc-IV_(Me%2cCb%2cC16-0).svg.png)
.svg/120px-NodARc-IV_(Me%2cCb%2cC16-0%2cFuc).svg.png)
.svg/120px-NodARc-IV_(Me%2cCb%2cC18-0).svg.png)
.svg/120px-NodARc-IV_(Me%2cCb%2cC18-0%2cFuc).svg.png)
.svg/120px-NodARc-IV_(Me%2cCb%2cC18-0%2cFuc%2cAra).svg.png)
.svg/120px-NodARc-IV_(Me%2cCb%2cC18-1).svg.png)
.svg/120px-NodARc-IV_(Me%2cCb%2cC18-1%2cFuc).svg.png)
.svg/120px-NodARc-IV_(Me%2cCb%2cC18-1%2cFuc%2cAra).svg.png)
.svg/120px-NodARc-V_(Me%2cC16-0).svg.png)
.svg/120px-NodARc-V_(Me%2cCb%2cC16-0).svg.png)
.svg/120px-NodARc-V_(Me%2cC18-0).svg.png)
.svg/120px-NodARc-V_(Me%2cCb%2cC18-0).svg.png)
Ara).svg/120px-NodARc-V_(Me%2cCb%2cC18-0%2c(C3)Ara).svg.png)
Ara).svg/120px-NodARc-V_(Me%2cCb%2cC18-0%2c(C6)Ara).svg.png)
.svg/120px-NodARc-V_(Me%2cCb%2cC18-0%2cFuc).svg.png)
.svg/120px-NodARc-V_(Me%2cCb%2cC18-0%2cFuc%2cAra).svg.png)
.svg/120px-NodARc-V_(Me%2cC18-1).svg.png)
.svg/120px-NodARc-V_(Me%2cCb%2cC18-1).svg.png)
Ara).svg/120px-NodARc-V_(Me%2cCb%2cC18-1%2c(C3)Ara).svg.png)
Ara).svg/120px-NodARc-V_(Me%2cCb%2cC18-1%2c(C6)Ara).svg.png)
.svg/120px-NodARc-V_(Me%2cCb%2cC18-1%2cFuc).svg.png)
.svg/120px-NodARc-V_(Me%2cCb%2cC18-1%2cFuc%2cAra).svg.png)
.svg/120px-NodBj-IV_(C18-1%2cMeFuc).svg.png)
.svg/120px-NodBj-IV_(Cb%2cC18-1%2cMeFuc).svg.png)
.svg/120px-NodBj-IV_(C18-1%2cFuc%2cGro).svg.png)
.svg/120px-NodBj-IV_(Me%2cC18-1%2cFuc%2cGro).svg.png)
.svg/120px-NodBj-IV_(Cb%2cC18-1%2cFuc%2cGro).svg.png)
.svg/120px-NodBj-IV_(Me%2cCb%2cC18-1%2cFuc%2cGro).svg.png)
.svg/120px-NodBj-V_(C16-0%2cMeFuc).svg.png)
.svg/120px-NodBj-V_(Ac%2cC16-0%2cMeFuc).svg.png)
.svg/120px-NodBj-V_(C16-1%2cMeFuc).svg.png)
.svg/120px-NodBj-V_(C18-1%2cMeFuc).svg.png)
.svg/120px-NodBj-V_(Ac%2cC18-1%2cMeFuc).svg.png)
.svg/120px-NodBj-V_(Cb%2cAc%2cC18-1%2cMeFuc).svg.png)
.svg/120px-NodBj-V_(Me%2cCb%2cC18-1%2cMeFuc).svg.png)
.svg/120px-NodMl-V_(Me%2cC18-1%2cFuc).svg.png)
.svg/120px-NodMl-V_(Me%2cCb%2cC18-1%2cFuc).svg.png)
.svg/120px-NodMl-V_(Me%2cCb%2cC18-1%2cAcFuc).svg.png)
.svg/120px-NodRe-V_(Me%2c18-0%2cAcFuc).svg.png)
.svg/120px-NodRe-V_(Me%2cCb%2c18-0%2cAcFuc).svg.png)
.svg/120px-NodRe-V_(Me%2c18-1%2cAcFuc).svg.png)
.svg/120px-NodRe-V_(Me%2cCb%2c18-1%2cAcFuc).svg.png)
.svg/120px-NodRlv-IV_(Ac%2cC18-1).svg.png)
.svg/120px-NodRlv-IV_(Ac%2cC18-4).svg.png)
.svg/120px-NodRlv-V_(Ac%2cC18-1).svg.png)
.svg/120px-NodRlv-V_(Ac%2cC18-4).svg.png)
.svg/120px-NodRt-V_(Me%2c18-1).svg.png)
.svg/120px-NodRt-V_(Me%2c18-1%2cS).svg.png)
.svg/103px-NodSf-III_(C18-1%2cFuc).svg.png)
.svg/103px-NodSf-III_(C18-1%2cMeFuc).svg.png)
.svg/120px-NodSf-IV_(C18-1%2cFuc).svg.png)
.svg/120px-NodSf-IV_(C18-1%2cMeFuc).svg.png)
.svg/120px-NodSf-V_(C18-1%2cFuc).svg.png)
.svg/120px-NodSf-V_(C18-1%2cMeFuc).svg.png)
.svg/116px-NodSm-III_(C16-1%2cS).svg.png)
.svg/112px-NodSm-III_(Ac%2cC16-1%2cS).svg.png)
.svg/116px-NodSm-III_(C16-2%2cS).svg.png)
.svg/112px-NodSm-III_(Ac%2cC16-2%2cS).svg.png)
.svg/115px-NodSm-III_(C16-3%2cS).svg.png)
.svg/112px-NodSm-III_(Ac%2cC16-3%2cS).svg.png)
.svg/120px-NodSm-IV_(C16-1%2cS).svg.png)
.svg/120px-NodSm-IV_(Ac%2cC16-1%2cS).svg.png)
.svg/120px-NodSm-IV_(C16-2%2cS).svg.png)
.svg/120px-NodSm-IV_(Ac%2cC16-2%2cS).svg.png)
.svg/120px-NodSm-IV_(C16-3%2cS).svg.png)
.svg/120px-NodSm-IV_(Ac%2cC16-3%2cS).svg.png)
%2cS).svg/120px-NodSm-IV_(Ac%2cC18-0(omega-1)%2cS).svg.png)
.svg/120px-NodSm-IV_(Ac%2cC18-1%2cS).svg.png)
%2cS).svg/120px-NodSm-IV_(Ac%2cC20-0(omega-1)%2cS).svg.png)
.svg/120px-NodSm-IV_(Ac%2cC20-1%2cS).svg.png)
%2cS).svg/116px-NodSm-IV_(Ac%2cC22-0(omega-1)%2cS).svg.png)
%2cS).svg/108px-NodSm-IV_(Ac%2cC24-0(omega-1)%2cS).svg.png)
%2cS).svg/101px-NodSm-IV_(Ac%2cC26-0(omega-1)%2cS).svg.png)
.svg/120px-NodSm-V_(C16-1%2cS).svg.png)
.svg/120px-NodSm-V_(Ac%2cC16-1%2cS).svg.png)
.svg/120px-NodSm-V_(C16-2%2cS).svg.png)
.svg/120px-NodSm-V_(Ac%2cC16-2%2cS).svg.png)
.svg/120px-NodSm-V_(C16-3%2cS).svg.png)
.svg/120px-NodSm-V_(Ac%2cC16-3%2cS).svg.png)















_skeleton.JPG/90px-Gastornis_(Diatryma)_skeleton.jpg)




















































.JPG/120px-Archelon_ischyros_(dorsal_view).jpg)
.JPG/90px-Archelon_ischyros_(ventral_view).jpg)







.png/120px-Debt-to-GDP_ratio_(1790_to_2009).png)

_and_Debt_(as_Percent_GDP)_Graph.png)
.png/120px-US_Federal_Debt_(1940_to_2009).png)
.png/120px-US_Federal_Debt_as_Percent_of_GDP_by_President_(1940_to_2012).png)
.png/120px-Total_US_Federal_Debt_by_President_(1940_to_2013).png)
.png)
.png/120px-Total_US_Federal_Debt_by_House_Majority_Party_(1940_to_2009).png)
.png)
.png/120px-Total_US_Federal_Debt_by_Senate_Majority_Party_(1940_to_2009).png)
.png/120px-United_States_Health_Gross_Care_Expenditures_(1960_to_2008).png)
.png)



















































































.png/94px-Indeterminate_Nodule_Zonation_(labeled).png)

































.svg/120px-2007_Organic_Farms_(Dairy_Cows_per_State_Acre).svg.png)


















































































































































































































































































































































































































.svg/120px-Red_and_Blue_States_Map_(Average_Margins_of_Presidential_Victory).svg.png)
























































































































_of_pear.png/120px-Fire_blight_(Erwinia_amylovora)_of_pear.png)


.JPG/120px-Mesorhizobium_loti_strain_MAFF303099_on_TY_agar_(clean).jpg)
.JPG/120px-Pseudomonas_fluorescens_on_TY_agar_(white_light).jpg)
.JPG/120px-Pseudomonas_fluorescens_on_TY_agar_(UV_light).jpg)

.JPG/120px-Sinorhizobium_fredii_strain_USDA257_on_TY_agar_(clean).jpg)

.JPG/120px-Aspergillus_sp._4.5X_(1).jpg)
.JPG/120px-Aspergillus_sp._4.5X_(2).jpg)
.JPG/120px-Aspergillus_sp._4.5X_(3).jpg)

.png/120px-Aureobasidium_spores_40X_(1).png)
.png/120px-Aureobasidium_spores_40X_(2).png)







.png/120px-Botrytis_conidiophores_4.5X_(2).png)



_plate.png/120px-Chaetonium_(Acremonium)_plate.png)
_perithecia_16X.png/120px-Chaetonium_(Acremonium)_perithecia_16X.png)
_perithecium_40X.png/120px-Chaetonium_(Acremonium)_perithecium_40X.png)
_ascospores_160X_(1).png/120px-Chaetonium_(Acremonium)_ascospores_160X_(1).png)
_ascospores_160X_(2).png/120px-Chaetonium_(Acremonium)_ascospores_160X_(2).png)

.png/120px-Curvularia_lesion_4.5X_(1).png)
.png/120px-Curvularia_lesion_4.5X_(2).png)

.png/120px-Curvularia_spores_160X_(1).png)
.png/120px-Curvularia_spores_160X_(2).png)
.png/120px-Dactylium_spores_160X_(1).png)
.png/120px-Dactylium_spores_160X_(2).png)

.png/120px-Fusarium_conidiophores_40X_(1).png)
.png/120px-Fusarium_conidiophores_40X_(2).png)

_plate.png/120px-Oidium_(Microsphaera)_plate.png)
_spores_160X.png/120px-Oidium_(Microsphaera)_spores_160X.png)

.png/120px-Penicillium_spores_160X_(1).png)

.png/120px-Penicillium_digitatum_conidiophores_40X_(1).png)
.png/120px-Penicillium_digitatum_conidiophores_40X_(2).png)
.png/120px-Penicillium_expansum_conidiophores_40X_(1).png)
.png/120px-Penicillium_expansum_conidiophores_40X_(2).png)

.png/120px-Pyrenophora_seminiperda_on_cheatgrass_2.5X_(1).png)
.png/120px-Pyrenophora_seminiperda_on_cheatgrass_2.5X_(2).png)

_40X.png/120px-Sordaria_fimicola_perithecium_(heterozygote)_40X.png)
_40X.png/120px-Sordaria_fimicola_perithecium_(tan_mutant)_40X.png)
_40X.png/120px-Sordaria_fimicola_perithecium_(wild-type)_40X.png)
_160X.png/120px-Sordaria_fimicola_ascus_(heterozygote)_160X.png)

.png/120px-Tilletiopsis_spores_160X_(1).png)
.png/120px-Tilletiopsis_spores_160X_(2).png)

.png/120px-Ulocladium_conidiophores_160X_(1).png)
.png/120px-Ulocladium_conidiophores_160X_(2).png)
_cleistothecium_4X.png/120px-Uncinula_(Oidium)_cleistothecium_4X.png)
_cleistothecium_40X_(1).png/120px-Uncinula_(Oidium)_cleistothecium_40X_(1).png)
_cleistothecium_40X_(2).png/120px-Uncinula_(Oidium)_cleistothecium_40X_(2).png)
_cleistothecium_160X.png/120px-Uncinula_(Oidium)_cleistothecium_160X.png)































.JPG/90px-Periodic_Spring_(from_the_bottom).jpg)
.JPG/120px-Periodic_Spring_(in_the_middle).jpg)
.JPG/90px-Periodic_Spring_(from_the_top).jpg)
.svg/120px-Therblig_(Deutsch).svg.png)
.svg/120px-Therblig_(English).svg.png)
.svg/120px-Therblig_(Espa%c3%b1ol).svg.png)

.svg/120px-Therblig_(Portugu%c3%aas).svg.png)
.svg/120px-Therblig_(Tagalog).svg.png)









_(clean).jpg/88px-Medicago_arabica%e2%80%94Flora_Batava_(1849)_(clean).jpg)
.jpg/69px-Medicago_carstiensis%e2%80%94Nicolai_Josephi_Jacquin_(clean).jpg)







_(Clean).jpg/80px-Medicago_lupulina%e2%80%94Flora_Batava._Volume_3_(1814)_(Clean).jpg)




_()
_(clean).jpg/94px-Medicago_polymorpha%e2%80%94Flora_Batava_(1881)_(clean).jpg)
.jpg/73px-Medicago_prostrata%e2%80%94Nicolai_Josephi_Jacquin_(clean).jpg)


_(clean).jpg/94px-Medicago_sativa%e2%80%94Flora_Batava_(1881)_(clean).jpg)


_(clean).jpg/90px-Medicago_falcata%e2%80%94Flora_Batava_(1868)_(clean).jpg)


_(clean).jpg/92px-Medicago_x_varia%e2%80%94Flora_Batava_(1901)_(clean).jpg)



_(Clean).jpg/88px-Trigonella_corniculata%e2%80%94Flora_Batava._Volume_3_(1814)_(Clean).jpg)

.jpg/91px-Medicago_species_1%e2%80%94La_flore_et_la_pomone_fran%c3%a7aises_(clean).jpg)
.jpg/92px-Medicago_species_2%e2%80%94La_flore_et_la_pomone_fran%c3%a7aises_(clean).jpg)
.jpg/103px-Medicago_species_3%e2%80%94La_flore_et_la_pomone_fran%c3%a7aises_(clean).jpg)
.jpg/96px-Medicago_species_4%e2%80%94La_flore_et_la_pomone_francaises_(clean).jpg)









.ogv/120px--Mimosa_pudica_rapid_movement_1_(full).ogv.jpg)
.ogv/120px--Mimosa_pudica_rapid_movement_2_(full).ogv.jpg)